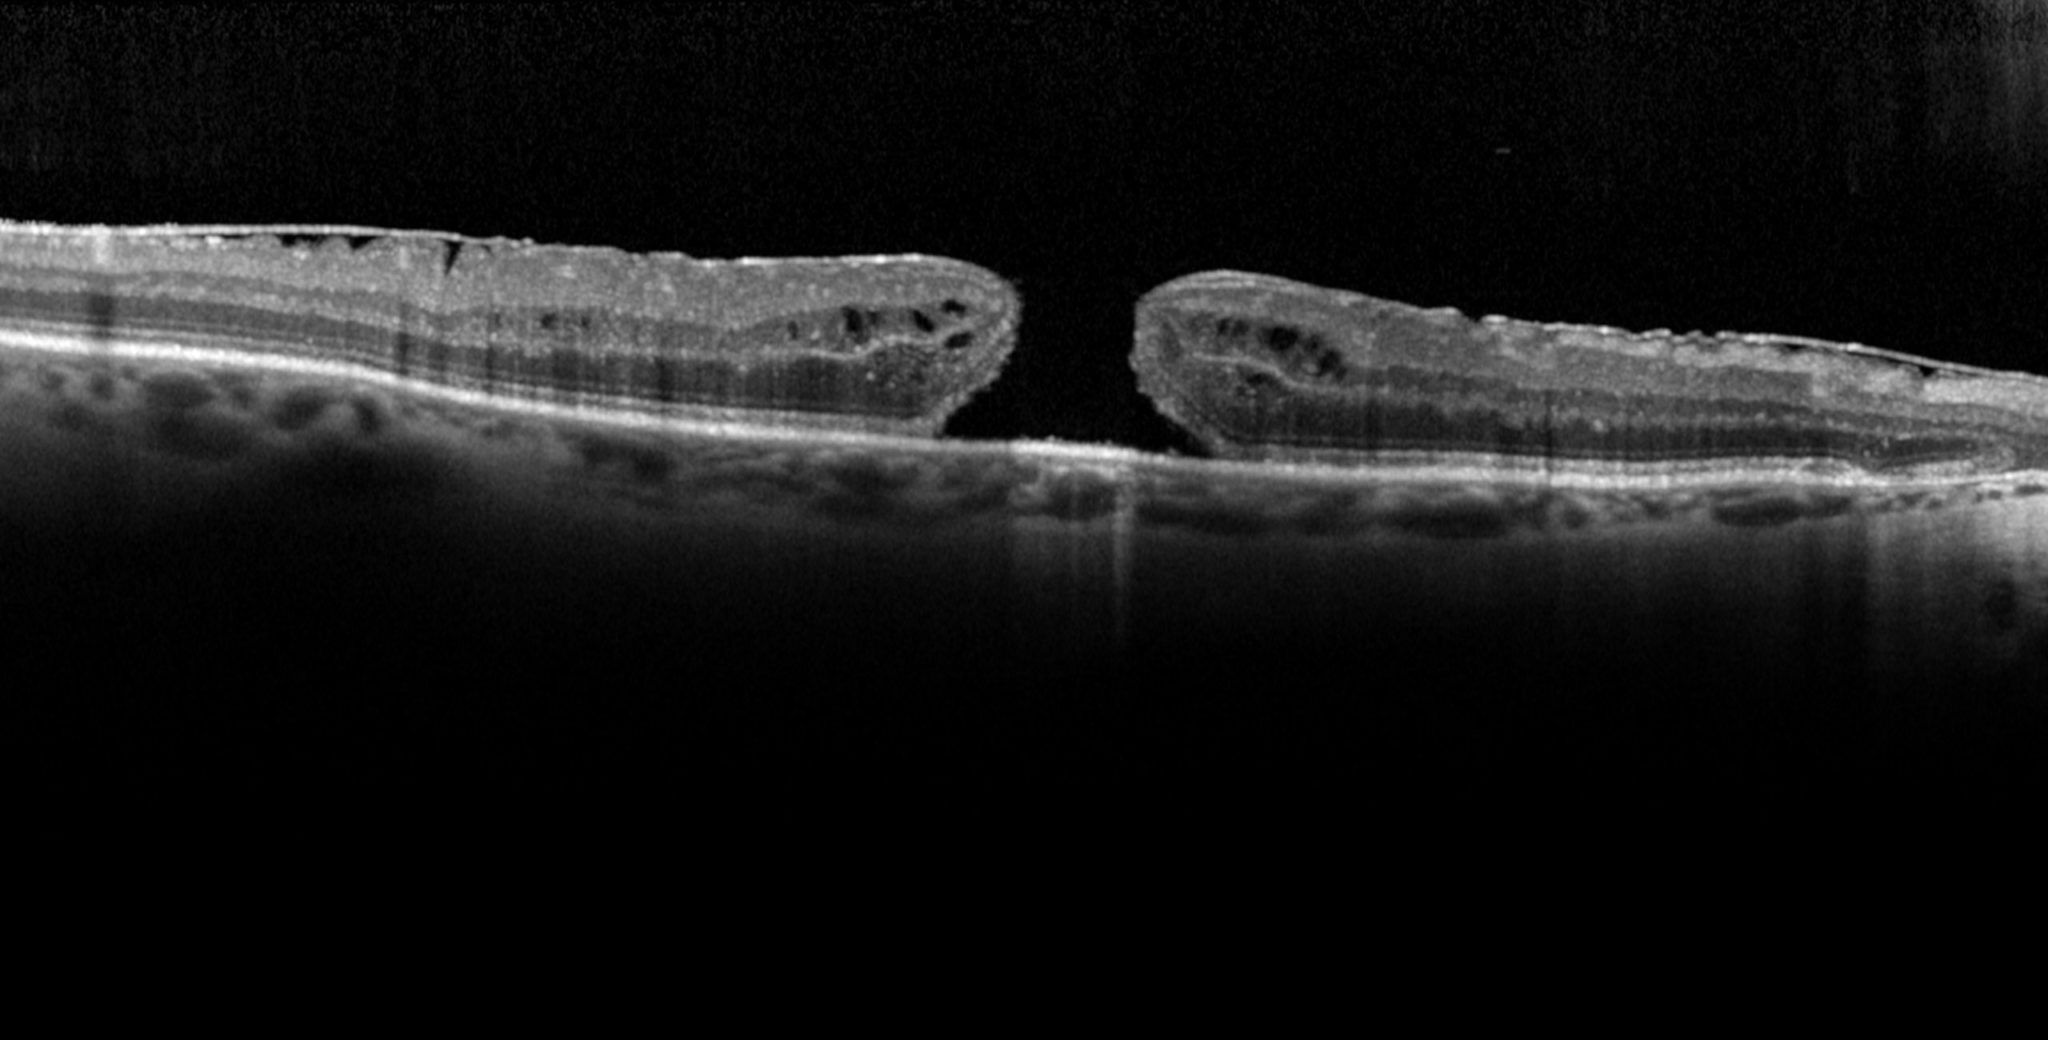
Trou maculaire : causes et traitements | Prix opération trou maculaire | Ophtalmologie | COPYV | Plaisir

Trou Maculaire
Le trou maculaire, une affection rare de l’œil, se présente comme une altération spécifique de la rétine, engendrant des implications significatives pour la vision. Ce trouble, bien qu’il puisse sembler minuscule, peut avoir des répercussions majeures sur la qualité de la vision. Dans cette exploration, nous allons discuter de la définition du trou maculaire, examiner les causes sous-jacentes, identifier les groupes de personnes susceptibles d’être touchées, et enfin, découvrir les méthodes de détection et de traitement au sein du Centre Ophtalmologique Levallois-Perret (COLEV).

Commentaire
Laissez un commentaire et le Centre Ophtalmologique Levallois-Perret (COLEV) vous répondra au plus vite